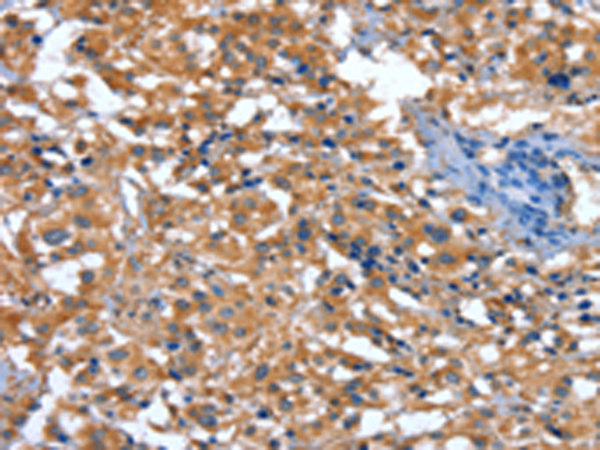

-
分类: 科研抗体货号: P11625别名: CINCIN1应用: IHC反应种属: Human
-
分类: 科研抗体货号: P11608别名:应用: WB,IHC反应种属: Human, Mouse, Rat
-
分类: 科研抗体货号: P11589别名: MGCA; DPPT-L应用: IHC反应种属: Human, Mouse, Rat
-
分类: 科研抗体货号: P11624别名: CARD4; NLRC1; CLR7.1应用: IHC反应种属: Human, Mouse
-
分类: 科研抗体货号: P11605别名: BSP; BNSP; SP-II; BSP-II应用: WB,IHC反应种属: Human, Mouse
-
分类: 科研抗体货号: P11588别名: FRP1; MEC1; SCKL; FCTCS; SCKL1应用: WB,IHC反应种属: Human
-
分类: 科研抗体货号: P11623别名: INCA应用: IHC反应种属: Human
-
分类: 科研抗体货号: P11604别名: FAM44B应用: IHC反应种属: Human, Mouse, Rat
-
分类: 科研抗体货号: P11587别名: MK; MNK; DSMAX; SMAX3应用: IHC反应种属: Human, Mouse, Rat
-
分类: 科研抗体货号: P11622别名: CD; ACUG; BLAU; IBD1; NLRC2; NOD2B; CARD15; CLR16.3; PSORAS1应用: IHC反应种属: Human

鄂公网安备42018502007531号
鄂公网安备42018502007531号

